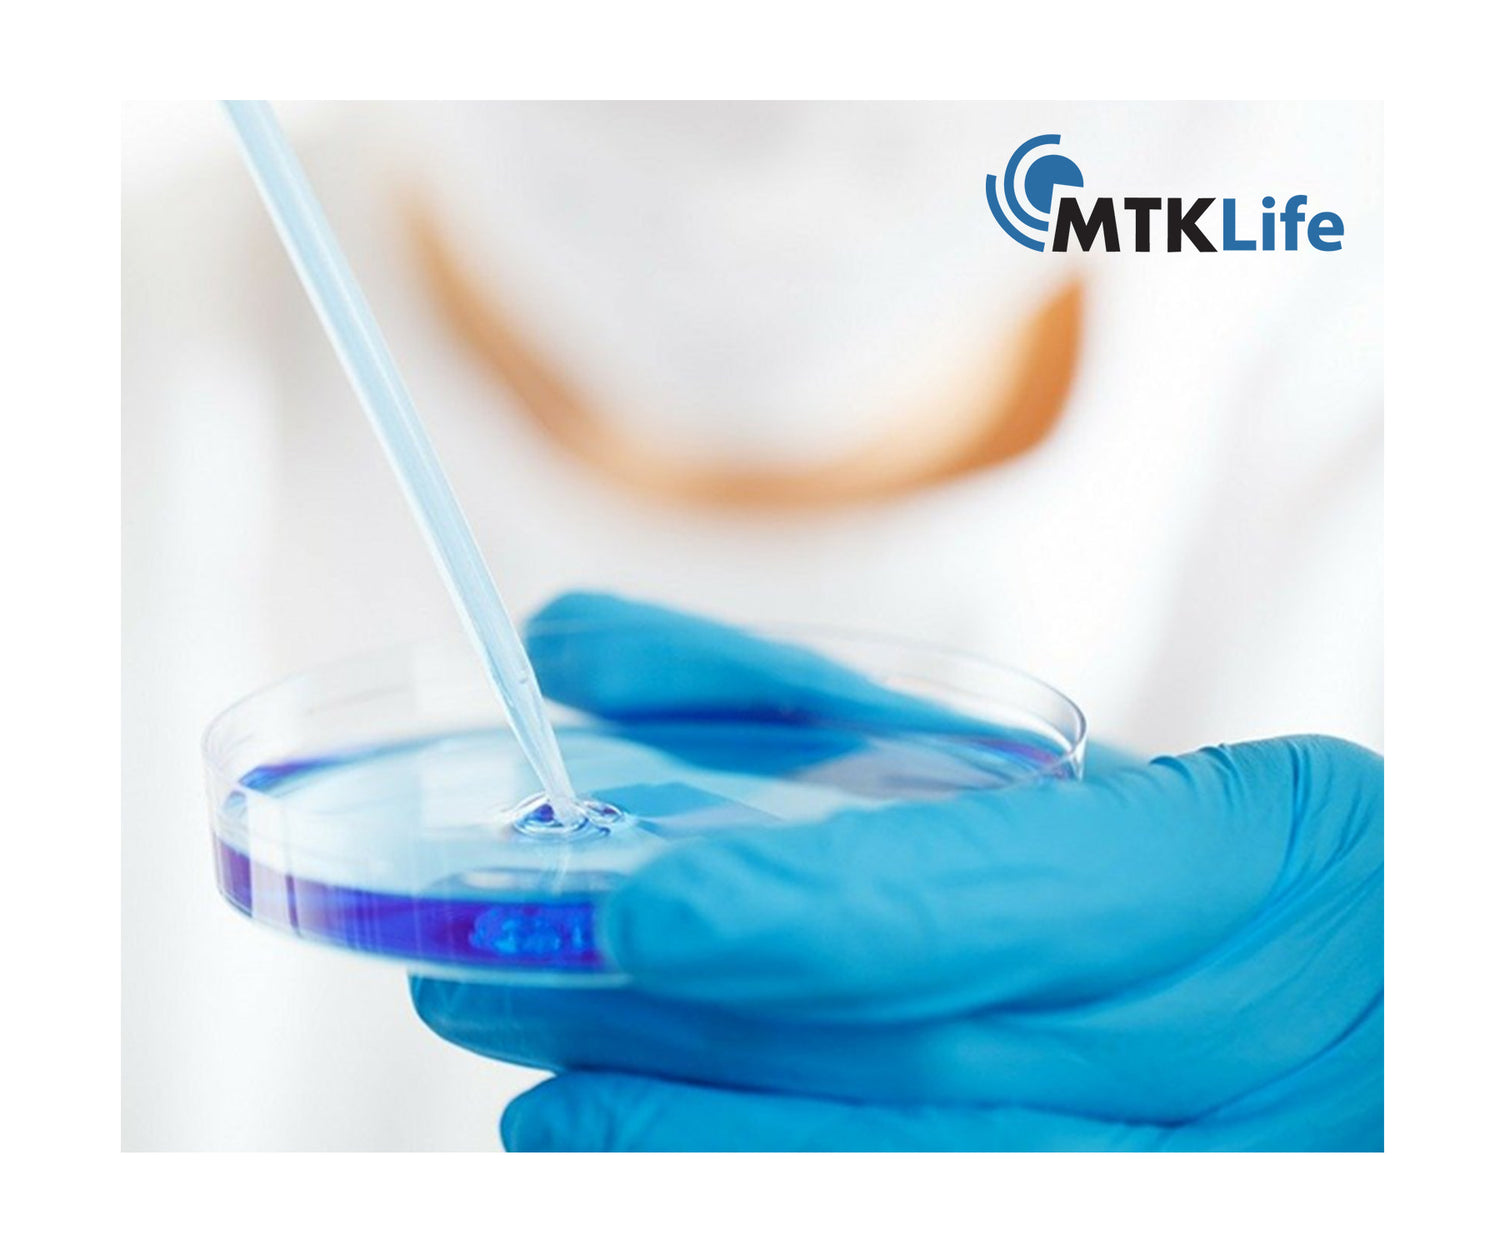

Est. 1993
30+ Years owning and operating multiple businesses across numerous industries worldwide.
Industries

Life at Santok
Fast-paced, innovative, and driven by a relentless pursuit of excellence in creating and delivering cutting-edge products and services across multiple industries.
Businesses

Since 2017
Mobile Reborn
Premium Refurbished Mobile Devices and Lifecycle Management.



Since 1999
STK Life
eCOA & ePRO customised smartphones, Tablets & Wearables for CRO's, Pharmaceutical, & Clinical Trial Equipment Suppliers.





